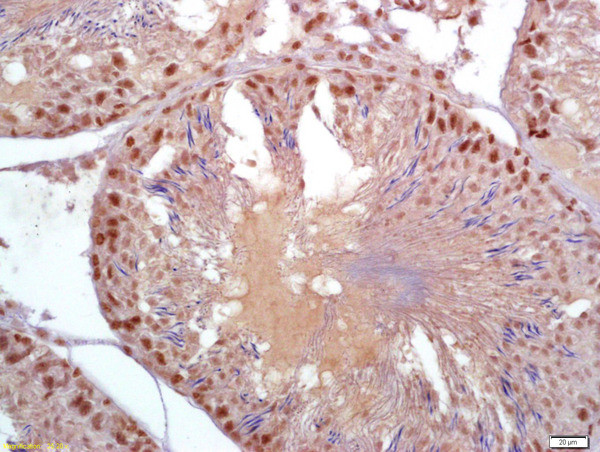
PARK2 Antibody in Immunohistochemistry (Paraffin) (IHC (P))

Search
Bioss
PARK2 Polyclonal Antibody
{{$productOrderCtrl.translations['antibody.pdp.commerceCard.promotion.promotions']}}
{{$productOrderCtrl.translations['antibody.pdp.commerceCard.promotion.viewpromo']}}
{{$productOrderCtrl.translations['antibody.pdp.commerceCard.promotion.promocode']}}: {{promo.promoCode}} {{promo.promoTitle}} {{promo.promoDescription}}. {{$productOrderCtrl.translations['antibody.pdp.commerceCard.promotion.learnmore']}}
产品信息
BS-1865R
种属反应
宿主/亚型
分类
类型
抗原
偶联物
形式
浓度
规格
纯化类型
保存液
内含物
保存条件
运输条件
靶标信息
The precise function of Parkin gene is unknown; however, the encoded protein is a component of a multiprotein E3 ubiquitin ligase complex that mediates the targeting of substrate proteins for proteasomal degradation. Mutations in this gene are known to cause Parkinson disease and autosomal recessive juvenile Parkinson disease. Alternative splicing of this gene produces multiple transcript variants encoding distinct isoforms. Additional splice variants of this gene have been described but currently lack transcript support.
仅用于科研。不用于诊断过程。未经明确授权不得转售。
篇参考文献 (0)
生物信息学
蛋白别名: E3 ubiquitin ligase; E3 ubiquitin protein ligase; parkin; E3 ubiquitin protein ligase; parkinson protein 2; E3 ubiquitin-protein ligase parkin; OTTHUMP00000017562; OTTHUMP00000017563; OTTHUMP00000017564; Parkin; parkin 2; Parkin isoform 1; parkin protein; Parkin RBR E3 ubiquitin-protein ligase; parkin variant SV5DEL; Parkinson disease (autosomal recessive, juvenile) 2, parkin; Parkinson disease protein 2; Parkinson juvenile disease protein 2; parkinson protein 2 E3 ubiquitin protein ligase; parkinson protein 2 E3 ubiquitin protein ligase (parkin) isoform PARK2_1; parkinson protein 2 E3 ubiquitin protein ligase (parkin) isoform PARK2_2; parkinson protein 2 E3 ubiquitin protein ligase (parkin) isoform PARK2_3; parkinson protein 2, E3 ubiquitin protein ligase; parkinson protein 2, E3 ubiquitin protein ligase (parkin); parkinson protein 2; E3 ubiquitin protein ligase; ubiquitin ligase E3; ubiquitin ligase E3; contains additional exon 1b between canonical exons 1 and 2; ubiquitin ligase E3; lacks exon 5; ubiquitin ligase E3; lacks exon 9; unnamed protein product
基因别名: AR-JP; LPRS2; Park; PARK2; PDJ; PRKN
UniProt ID: (Human) O60260, (Rat) Q9JK66, (Mouse) Q9WVS6
Entrez Gene ID: (Human) 5071, (Rat) 56816, (Mouse) 50873